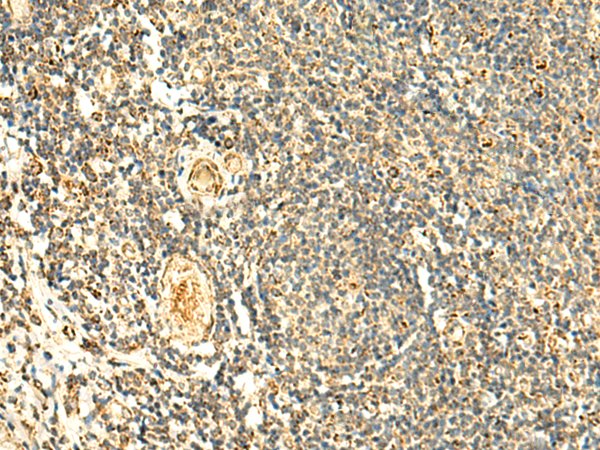

中文名稱:兔抗ATP5PD多克隆抗體
|
Background: |
Mitochondrial ATP synthase catalyzes ATP synthesis, utilizing an electrochemical gradient of protons across the inner membrane during oxidative phosphorylation. It is composed of two linked multi-subunit complexes: the soluble catalytic core, F1, and the membrane-spanning component, Fo, which comprises the proton channel. The F1 complex consists of 5 different subunits (alpha, beta, gamma, delta, and epsilon) assembled in a ratio of 3 alpha, 3 beta, and a single representative of the other 3. The Fo seems to have nine subunits (a, b, c, d, e, f, g, F6 and 8). This gene encodes the d subunit of the Fo complex. Alternatively spliced transcript variants encoding different isoforms have been identified for this gene. In addition, three pseudogenes are located on chromosomes 9, 12 and 15. |
|
Applications: |
ELISA, WB, IHC |
|
Name of antibody: |
ATP5PD |
|
Immunogen: |
Fusion protein of human ATP5PD |
|
Full name: |
ATP synthase peripheral stalk subunit d |
|
Synonyms: |
ATPQ; ATP5H |
|
SwissProt: |
O75947 |
|
ELISA Recommended dilution: |
5000-10000 |
|
IHC positive control: |
Human colorectal cancer and Human tonsil |
|
IHC Recommend dilution: |
50-300 |
|
WB Predicted band size: |
18 kDa |
|
WB Positive control: |
Mouse skeletal muscle tissue, Mouse kidney tissue, PC-3, Jurkat, HepG2 and Hela cell lysates |
|
WB Recommended dilution: |
500-2000 |

購物車
購物車 幫助
幫助
 021-54845833/15800441009
021-54845833/15800441009
